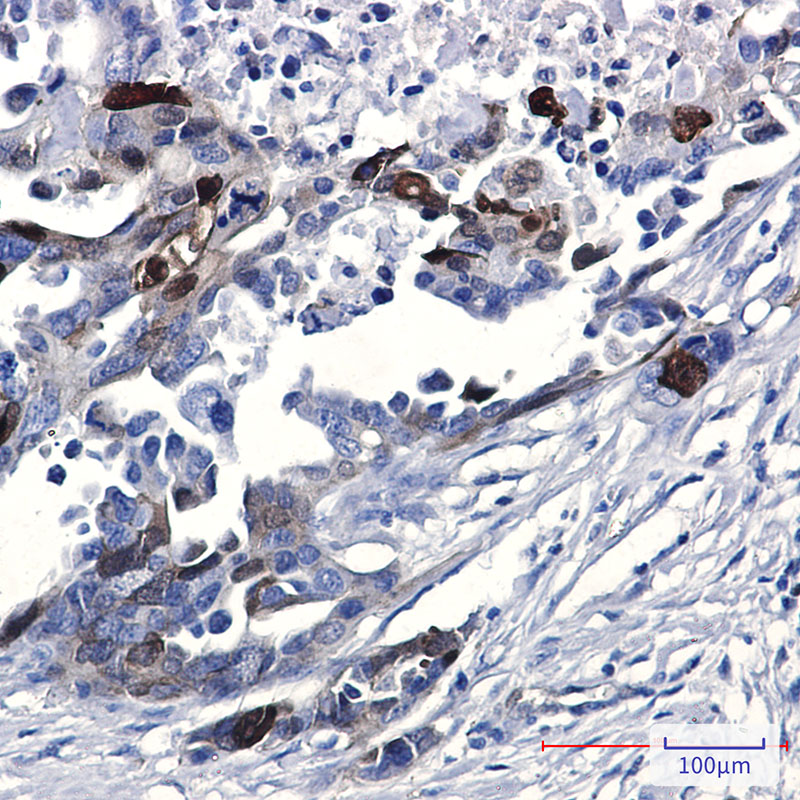

-
分类: 科研抗体货号: P20158别名: KIF22; KID; KNSL4; Kinesin-like protein KIF22; Kinesin-like DNA-binding protein; Kinesin-like protein 4应用: WB反应种属: Human
-
分类: 科研抗体货号: P20193别名: Protein kinase C delta type; Tyrosine-protein kinase PRKCD; nPKC-delta应用: WB,IP,IHC反应种属: Human
-
分类: 科研抗体货号: P20220别名: MAPK1/MAPK3应用: WB,IP反应种属: Human,Rat
-
分类: 科研抗体货号: P20191别名: TP53; P53; Cellular tumor antigen p53; Antigen NY-CO-13; Phosphoprotein p53; Tumor suppressor p53应用: WB,IP,IHC反应种属: Human
-
分类: 科研抗体货号: P20218别名: CREB; CREB-1应用: WB,IHC反应种属: Human,Rat
-
分类: 科研抗体货号: P20189别名: Protein NDRG1; Differentiation-related gene 1 protein; DRG-1; RTP; Rit42; NDRG1; CAP43; DRG1; RTP; targ1; TDD5; tdds应用: WB,IP,IHC,IF反应种属: Human,Mouse
-
分类: 科研抗体货号: P20215别名: NTRK2; TRKB; BDNF/NT-3 growth factors receptor; GP145-TrkB; Trk-B; Neurotrophic tyrosine kinase receptor type 2; TrkB tyrosine kinase; Tropomyosin-related kinase B应用: WB反应种属: Human,Mouse,Rat
-
分类: 科研抗体货号: P20188别名: MSN; Moesin; Membrane-organizing extension spike protein; RDX; Radixin; EZR; VIL2; Ezrin; Cytovillin; Villin-2; p81应用: WB,IHC反应种属: Human,Rat
-
分类: 科研抗体货号: P20213别名: H2A.X; H2AFX; H2a/x; HIST5-2AX; Histone H2A.X; gamma H2A.X应用: WB,IF反应种属: Human,Mouse
-
分类: 科研抗体货号: P20227别名: PRKCA; PKCA; PRKACA; Protein kinase C alpha type; PKC-A; PKC-alpha应用: WB,IHC反应种属: Human,Rat

鄂公网安备42018502007531号
鄂公网安备42018502007531号

